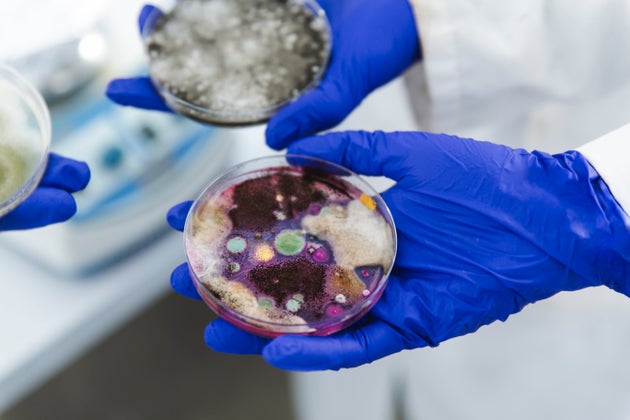

Σε υψόμετρο 3.000 πάνω από τη γη οι επιστήμονες εντόπισαν εκατοντάδες αερομεταφερόμενα μικρόβια
16/09/2024 - 10:33
Το Clostridium difficile, ένα βακτήριο που προκαλεί διάρροια, ήταν μεταξύ των παθογόνων μικροοργανισμών που βρέθηκαν στα αιωρούμενα σωματίδια σκόνης. Φωτ: Φωτογραφία: BSIP/Universal Images Group/Getty ImagesΜικρόβια που μπορούν να προκαλέσουν σοβαρές ασθένειες στον άνθρωπο έχουν την δυνατότητα να ταξιδέυουν χιλιάδες χιλιόμετρα με ανέμους υψηλού επιπέδου, όπως αποκάλυψαν για πρώτη φορά οι επιστήμονες.
Τη Δευτέρα, οι ερευνητές ανέφεραν ότι σε πτήσεις πάνω από την Ιαπωνία, σε υψόμετρο έως και 10.000 πόδια (3.000 μέτρα περίπου), είχαν συλλάβει εκατοντάδες διαφορετικούς τύπους βακτηρίων και μυκήτων. Η ομάδα υπολόγισε ότι τα μικρόβια είχαν πετάξει πάνω από 1.200 μίλια (1.930 χιλιόμετρα) όταν συνελήφθησαν.
«Το ένα τρίτο των βακτηρίων και λίγο περισσότεροι μύκητες μπορούν να θεωρηθούν δυνητικά παθογόνα για τον άνθρωπο», δήλωσε ο Xavier Rodó, πληροφορικός οικολόγος στο Ινστιτούτο Παγκόσμιας Υγείας της Βαρκελώνης, ο οποίος ηγήθηκε της εργασίας.
Ο Δρ Rodó προειδοποίησε ότι η νέα μελέτη δεν προσφέρει, ωστόσο, καμία άμεση απόδειξη ότι τα μικρόβια που βρίσκονται σε μεγάλο υψόμετρο θα μπορούσαν να προκαλέσουν ανθρώπινες επιδημίες όταν πέσουν στο έδαφος. Υποστήριξε όμως ότι προσφέρει ενδείξεις ότι οι άνεμοι συνέβαλαν στη διάδοση των ασθενειών. «Αυτό είναι κάτι που χρήζει προσοχής», είπε.
Η ιδέα για τις πτήσεις των μικροβίων προήλθε από την έρευνα του Δρ. Rodó σχετικά με μια μυστηριώδη πάθηση γνωστή ως νόσος Kawasaki, η οποία προκαλεί πυρετό, εξανθήματα και, μερικές φορές, θανατηφόρες καρδιακές προσβολές. Οι ερευνητές ψάχνουν εδώ και καιρό να καταλάβουν αν η ασθένεια προκαλείται από κάποιο παθογόνο, από ένα ελαττωματικό ανοσοποιητικό σύστημα ή από έναν συνδυασμό των δύο.
Τα κρούσματα της νόσου Kawasaki παρουσιάζουν έξαρση. Ο Δρ Rodó και οι συνεργάτες του διαπίστωσαν ότι τα κρούσματα στην Ιαπωνία εμφανίζονταν συχνά όταν έπνεαν άνεμοι από τη βορειοανατολική Κίνα. Και όταν οι ίδιοι άνεμοι έφταναν στην Καλιφόρνια, τα κρούσματα αυξάνονταν και εκεί.
«Δεν περιμέναμε ότι οι άνεμοι θα έπαιζαν πραγματικά ρόλο, αλλά προέκυψε με έναν τρόπο που ήταν πραγματικά εντυπωσιακός για μένα», δήλωσε ο Δρ Rodó.
Η περιοχή της Κίνας από την οποία προήλθαν οι άνεμοι έχει πολλά τεράστια αγροκτήματα και κτηνοτροφικές μονάδες, μαζί με ορυχεία ανοιχτού τύπου. Η έρευνα υπέδειξε ότι κάτι ταξίδευε με τους ανέμους – κάτι πιθανώς ζωντανό. «Έτσι σκέφτηκα, ας πάμε να κυνηγήσουμε ό,τι υπάρχει εκεί», δήλωσε ο Δρ Rodó.
Η ομάδα του πέταξε με ένα αεροπλάνο Cessna σε αέριες μάζες που έπνεαν από την Κίνα πάνω από τη Θάλασσα της Ιαπωνίας. Το αεροπλάνο ανέβηκε πάνω από την ταραχώδη κατώτερη ατμόσφαιρα, φτάνοντας στην ελεύθερη τροπόσφαιρα, ένα στρώμα όπου οι αέριες μάζες μπορούν να κινηθούν γρήγορα σε μεγάλες αποστάσεις. Μια είσοδος άνοιξε στο πλάι του αεροπλάνου, επιτρέποντας στον αέρα να ρέει σε έναν σωλήνα που οδηγούσε σε ένα φίλτρο όπου παγιδεύονταν τα αιωρούμενα σωματίδια.
Σε 10 πτήσεις συνολικά η ομάδα συγκέντρωσε δείγματα σε ύψος έως και 10.000 πόδια. Στη συνέχεια, οι ερευνητές μετέφεραν τα δείγματα στο εργαστήριό τους, όπου φόρεσαν στολές βιοασφάλειας και αναπνευστήρες για να αποφύγουν τη μόλυνση.
Ο Δρ. Rodó και οι συνάδελφοί του βρήκαν υψηλά επίπεδα ενός σπάνιου ορυκτού που ονομάζεται άφνιο, το οποίο πιθανώς προέρχεται από ορυχεία στην Κίνα.
Τα δείγματα περιείχαν επίσης σπόρια μυκήτων, μαζί με βακτήρια που κολλούσαν σε μικροσκοπικούς κόκκους σκόνης. Παρά το μακρύ ταξίδι των Μικροοργανισμών, ορισμένοι ήταν ακόμη ζωντανοί- κατάφεραν να αναπτυχθούν σε αποικίες σε τρυβλία Petri.
Όταν ο Δρ.. Rodó και οι συνεργάτες του εξήγαγαν DNA από τα μικρόβια, ανακάλυψαν τουλάχιστον 266 είδη μυκήτων και 305 είδη βακτηρίων. Πολλά από τα μικρόβια ανήκουν σε ομάδες που αναπτύσσονται στα φυτά ή στο έδαφος. Ορισμένα είναι ιδιαίτερα καλά στο να αναπτύσσονται σε βαριά μολυσμένο έδαφος. Άλλα ανήκουν σε ομάδες που είναι γνωστό ότι ζουν στο σώμα μας. Ορισμένα αποτελούν ειρηνικά μέλη του ανθρώπινου μικροβιώματος, ενώ άλλα μπορούν να προκαλέσουν επικίνδυνες λοιμώξεις.
Ο Δρ Rodó υπέθεσε ότι η βορειοανατολική Κίνα μπορεί να αποτελεί ισχυρή πηγή παθογόνων μικροοργανισμών εξαιτίας της μεγάλης κλίμακας καλλιεργειών και ζώων. Η διάβρωση μπορεί να παράγει μεγάλα σύννεφα σκόνης. Είναι πιθανό κάποια μικρόβια από το έδαφος – ή ακόμη και από λιπάσματα ή λύματα – να μπορούν να προκαλέσουν ασθένειες.
Ο Δρ Rodó δήλωσε ότι ο ίδιος και οι συνάδελφοί του προετοιμάζουν πειράματα για την έκθεση των δειγμάτων αέρα σε ανθρώπινα πνευμονικά κύτταρα.
Η νέα μελέτη δεν λύνει το μυστήριο της νόσου Kawasaki, δήλωσε ο Δρ Rodó. Είναι πιθανό ότι περισσότερα από ένα παθογόνα μπορεί να είναι σε θέση να πυροδοτήσουν τη νόσο- είναι επίσης πιθανό ότι τα παιδιά γίνονται ευάλωτα μόνο αν εισπνέουν ατμοσφαιρική ρύπανση που μεταφέρεται από τους ίδιους ανέμους. «Δεν γνωρίζουμε ακόμη τι συμβαίνει», δήλωσε ο Δρ Rodó.
Ο ίδιος και οι συνάδελφοί του χρησιμοποιούν τώρα νέες τεχνολογίες για να αναλύσουν τα δείγματά τους από την Ιαπωνία και βρίσκουν ενδείξεις για πρόσθετους οργανισμούς, συμπεριλαμβανομένων των ιών.
Ακόμα και αν ο Dr. Rodó και οι συνάδελφοί του βρουν σαφέστερες αποδείξεις για παθογόνους μικροοργανισμούς στους ανέμους, παραμένει ένα ανοιχτό ερώτημα κατά πόσον αυτά τα μικρόβια θα μπορούσαν να μεταδώσουν αξιόπιστα ασθένειες από τόπο σε τόπο. Τα παθογόνα που ταξιδεύουν στα 10.000 πόδια στον αέρα είναι πολύ πιο αραιά από αυτά που συσσωρεύονται όταν οι μολυσμένοι άνθρωποι εκπνέουν σε κτίρια με κακό εξαερισμό.
Παρόλα αυτά, «μερικές φορές, αρκεί μόνο ένα», δήλωσε ο Δρ Schmale. «Αυτοί είναι ανεξερεύνητοι περιβαλλοντικοί χώροι και πρέπει να τους μελετήσουμε περισσότερο».
Πηγή: Τhe New York Times
Πηγή: huffingtonpost
Σχετικά άρθρα
- Aντισηπτικά: Μάλλον ήρθε η ώρα να τα πετάξουμε - 3 αδιανόητοι κίνδυνοι που κρύβουν (0.577)
- Το σημείο με τα περισσότερα μικρόβια στο σούπερ μάρκετ - Και μάλλον δε έχει πάει ποτέ ο νους μας (0.577)
- Κλιματική αλλαγή: Η υπερθέρμανση «καίει» τον εγκέφαλό μας – Τι έχουν διαπιστώσει οι επιστήμονες (0.385)
- Ζάκυνθος: Θάνατος 74χρονου από λεπτοσπείρωση (0.384)
- Πάνω από 600 νέους ιούς ανίχνευσαν οι επιστήμονες σε ντους και οδοντόβουρτσες (0.289)
Δημοσίευση από AutoPolis, Βρίσκεται στις κατηγορίες Τελευταία νέα

Εμείς και εσείς σε επαφή




